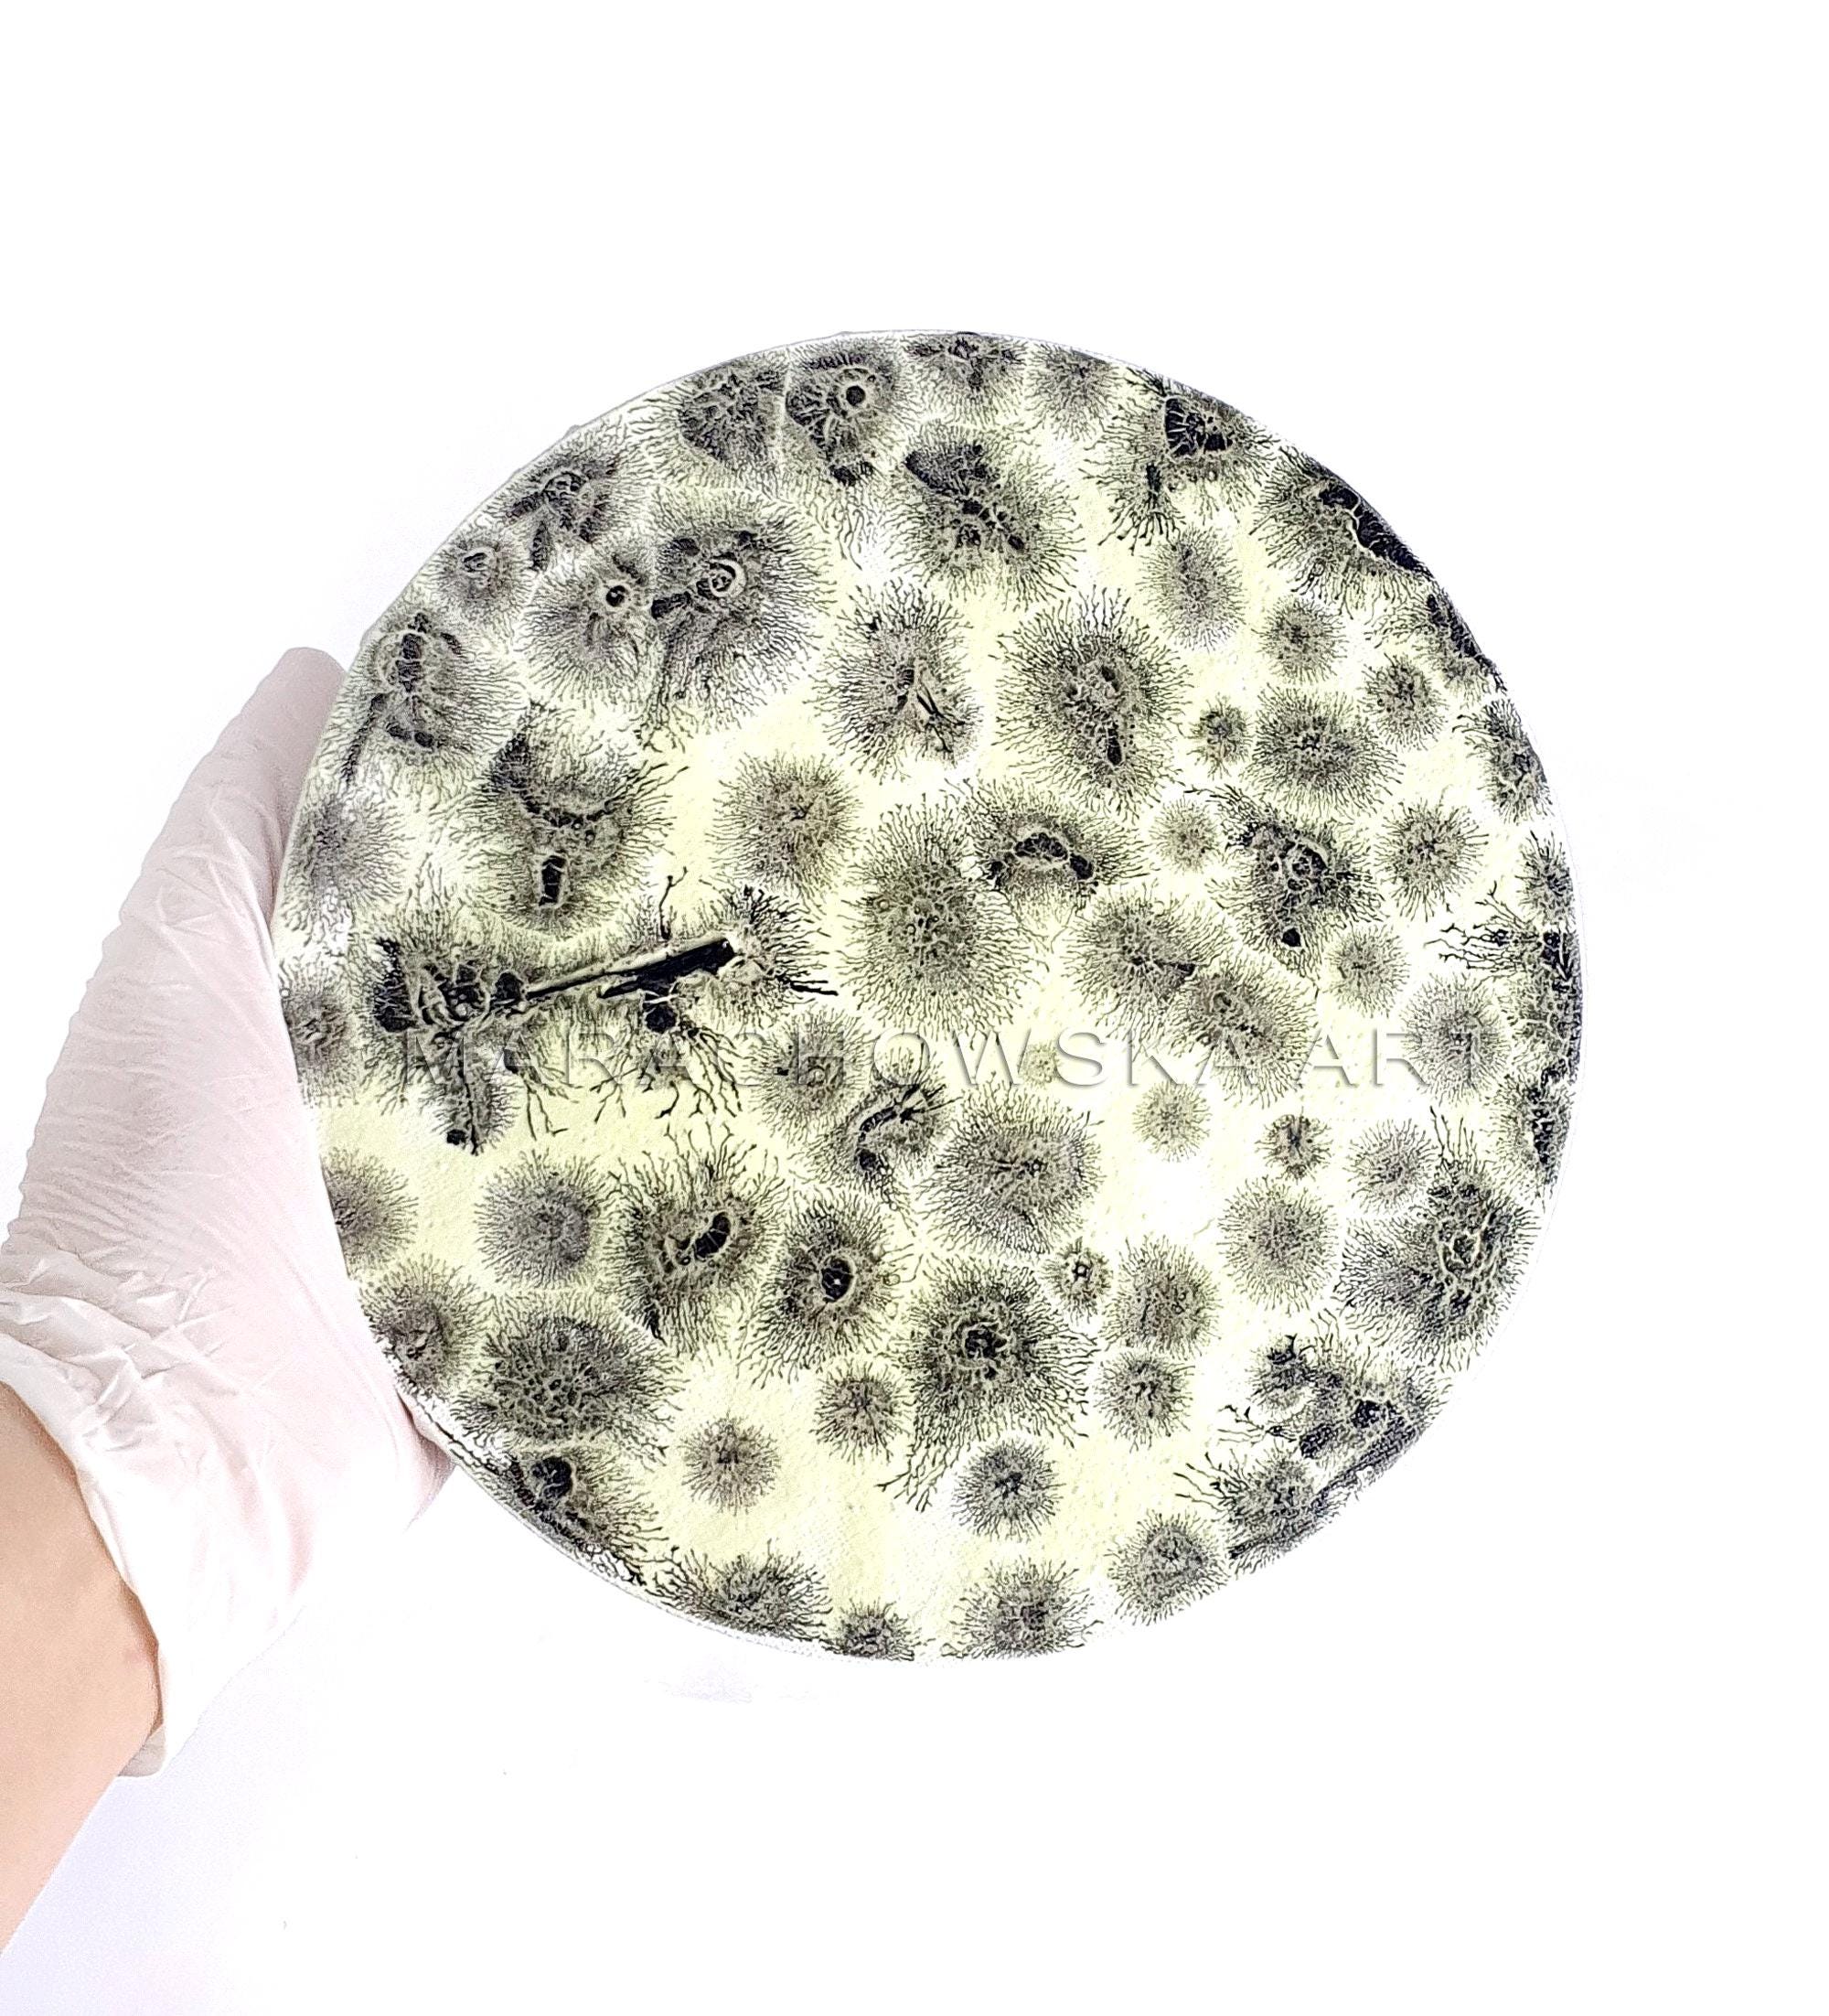

The original painting "Magic Moon" was created by Maria Marachowska in 2021. This extraordinary, abstract acrylic painting is unique in its form and design. The colors, which glow in the dark and in blacklight, and the round format of the canvas bring a touch of the universe into your home. A true work of art that will inspire you again and again.
CANVAS PAINTING: https://www.etsy.com/shop/MARACHOWSKAART?section_id=29696988
ARTWORK DESCRIPTION:
- Glow in the dark
- Acryl Winsor & Newton
- Canvas
- Final Varnish Liquitex
- Painting Size: 20 × 20 x 6 cm
- Ready to hang
- Sun & Water Resistant Colors
- 1 Piece in the World! Only Original!
- Certificate of Authenticity originally signed by the Painter
- UV-resistant
- Environmentally friendly and sustainable production
USE:
- Wall Decoration
SHIPPING:
- Safe and secure worldwide shipping, cardboard packaged and additionally protected in bubble wrap
- with tracking number (International + EU)
For Maria Marachowska painting represents an act of liberation, when she immerses into the element of art, the empty canvas or a sheet of paper means infinity to her. In her artistic expression, she knows no boundaries, the painter’s brush in her hand seems to take on a life of its own, becomes the key to an intensely personal, mysterious world. When she paints, she draws from the strength of her rich memories and her experience of life, quite remarkable for an artist as young as herself and capable of touching us just through their truthfulness and authenticity.
In her works, her experiences are transformed into pure energy and emotions which are transmitted to the spectator, it is impossible to withdraw from the deep attraction of her images, they virtually absorb through their oscillating, often almost hallucinatory colours and their suggestive shapes. It is her artistic credo not to adjust whatsoever to anything that has existed, she cannot be assigned to any existing art style, her works speak of universal forces, far beyond any conventions. Inspiration comes from within herself, from her innermost feelings, her joys and pains which she transfers into her visionary image compositions, as if to relieve of an oppressive burden – creation is a basic need to her, inseparably linked with her life.
The process of her artistic work is only comparable to a natural phenomenon: the wave effect and extension, caused by a pebble that touches the water surface and spins apparently infinite circles, one arises from the other, a constant development and renovation, generating always new, innovative art works and image series. Maria Marachowska’s art is cosmic, seems to be connected to the stars, abstraction opens new dimensions of perception, something sacred and sublime is inherent to her oeuvre, radiates a healing power
The apocalyptic air, penetrating to the surface in many of her paintings, gives no reason to anguish or grief, but announces a new world in which the Fantastic has defeated cold rationality, through the awakening of an all-embracing cosmos, she gives reason to hope, her images give us a hint of a lost world before the beginning of time, to which there is no more access in normal life.
Having discovered the special art of glass painting for herself through a commissioned work for one of her collectors in 2011, Maria Marachowska has made this technique her own and developed it to perfection. The way she transfers her unique painting style from paper and canvas to transparency blasts the boundaries of traditional material properties, conveying the impression of alchemic power. A medium more commonly associated with ecclesial context or art-deco inspired design, glass painting has been transformed into a totally new art form in Maria Marachowska's recent works. Whereas in Tiffany objects, metal is used as separating element, she generates the same effect through the delicate application of relief paste, an enticing allusion to the assumed characteristics of stained glass art. © Text: Iris Weirich
I look forward to your reviews!
Thanks very much!
Terms & Conditions and Right of Withdrawal
Shipping from Germany
Processing time
1-2 business days
Customs and import taxes
Buyers are responsible for any customs and import taxes that may apply. I'm not responsible for delays due to customs.
Payment Options
Returns & Exchanges
Returns & exchanges accepted within 14 days
Buyers are responsible for return shipping costs. If the item is not returned in its original condition, the buyer is responsible for any loss in value.
I gladly accept returns, exchanges, and cancellations
Request a cancellation within: 1 hours of purchase
The following items can't be returned or exchanged
Because of the nature of these items, unless they arrive damaged or defective, I can't accept returns for:
- Custom or personalized orders
- Perishable products (like food or flowers)
- Digital downloads
- Intimate items (for health/hygiene reasons)
- Items on sale
Questions about your order?
Please contact me if you have any problems with your order.
Privacy policy
General terms and conditions with customer information & information on data protection & cancellation policy & cancellation form
–––––––––––––––––––––––––––––––––––––––––––––––––––––––––––––––––––––––––––––––––––––––––––––––––––––––––––––––––––
Table of contents
–––––––––––––––––––––
A. General terms and conditions with customer information
–––––––––––––––––––––––––––––––––––––––––––––––––––––––––––––––––––––––––––––––––
1. Scope of application
2. Conclusion of contract
3. Right of withdrawal
4. Prices and payment terms
5. Delivery and shipping conditions
6. Granting of rights of use for digital content
7. Retention of title
8. Liability for defects
9. Liability
10. Special conditions for the processing of goods according to specific customer specifications
11. Applicable law
12. Alternative dispute resolution
B. Information on data protection
–––––––––––––––––––––––––––––––––––––
1. Information on the collection of personal data and contact details of the person responsible
2. Contact
3. Data processing for order processing
4. Web analysis services
5. Rights of the data subject
6. Duration of storage of personal data
7. Reference to the Etsy data protection declaration
C. Cancellation policy
––––––––––––––––––––––––
1. Right of withdrawal
2. Consequences of cancellation
3. Exclusion or premature expiration of the Right of withdrawal
D. Cancellation form
–––––––––––––––––––––––
––––––––––––––––––––––––––––––––––––––––––––––––––––––––––––––––––––––––––––––––
A. General terms and conditions with customer information
–––––––––––––––––––––––––––––––––––––––––––––––––––––––––––––––––––––––––––
1) Scope
1.1 These general terms and conditions (hereinafter "GTC") of Maria Kuznetsova, trading under "Marachowska ART" (hereinafter "Seller"), apply to all contracts for the delivery of goods that a consumer or entrepreneur (hereinafter "Customer") concludes with the Seller in relation to the goods offered by the Seller on the internet trading platform Etsy (hereinafter "Etsy"). The inclusion of the customer's own terms and conditions is hereby contradicted, unless otherwise agreed.
1.2 These terms and conditions apply accordingly to contracts for the delivery of physical data carriers that serve exclusively as carriers of digital content, unless otherwise stipulated. Digital content within the meaning of these terms and conditions is data that is created and provided in digital form.
1.3 These terms and conditions apply accordingly to contracts for the provision of digital content, unless otherwise stipulated. Digital content within the meaning of these terms and conditions is data that is created and provided in digital form.
1.4 These terms and conditions apply accordingly to contracts for the delivery of vouchers, unless otherwise stipulated.
1.5 A consumer within the meaning of these terms and conditions is any natural person who concludes a legal transaction for purposes that cannot predominantly be attributed to their commercial or independent professional activity.
1.6 An entrepreneur within the meaning of these terms and conditions is a natural or legal person or a partnership with legal capacity who, when concluding a legal transaction, acts in the exercise of their commercial or independent professional activity.
2) Conclusion of contract
2.1 By listing an item on Etsy, the seller makes a binding offer to sell this item.
2.2 The customer can accept the seller's offer using the online order form provided by Etsy. To do this, the customer must first place the desired item in the virtual shopping cart on Etsy and then go through the ordering steps specified by Etsy. By clicking on the button that concludes the ordering process, the customer declares acceptance of the offer, which creates a purchase contract for the goods previously selected by the customer.
2.3 The text of the contract is saved by the seller and sent to the customer after the contract has been concluded, together with these terms and conditions and customer information, in text form (e.g. email, fax or letter). The seller himself will not make the text of the contract available beyond this.
2.4 Before placing the order, the customer can identify possible input errors by carefully reading the information displayed on the screen. An effective technical means for better identifying input errors can be the browser's zoom function, which helps to enlarge the display on the screen. The customer can correct his entries before placing the order as part of the electronic ordering process using the usual keyboard and mouse functions.
2.5 Only the German language is available for concluding the contract.
3) Right of withdrawal
3.1 Consumers are generally entitled to a right of withdrawal.
3.2 More information on the right of withdrawal can be found in the seller's cancellation policy.
4) Prices and payment conditions
4.1 The prices stated by the seller are total prices. Sales tax is not shown because the seller is a small business within the meaning of Section 19 Paragraph 1 of the VAT Act. Any additional delivery and shipping costs are stated separately in the respective product description.
4.2 For deliveries to countries outside the European Union, additional costs may arise in individual cases for which the seller is not responsible and which must be borne by the customer. These include, for example, costs for the transfer of money by credit institutions (e.g. transfer fees, exchange rate fees) or import duties or taxes (e.g. customs duties). Such costs may also arise in relation to the transfer of money if the delivery is not made to a country outside the European Union, but the customer makes the payment from a country outside the European Union.
4.3 The payment option(s) will be communicated to the customer in the seller's offer on Etsy.
4.4 When paying using a payment method offered via the payment service "Etsy Payments", payment processing takes place via Etsy Ireland UC, 66/67 Great Strand Street, Dublin 1, Ireland (hereinafter "Etsy UC") or - if payment is made in US dollars or Canadian dollars - via Etsy Inc., 117 Adams Street, Brooklyn, NY 11201, United States of America (hereinafter "Etsy Inc."). Etsy UC or Etsy Inc. enables the customer to use various payment methods as part of the payment processing via Etsy Payments. Etsy UC or Etsy Inc. can use third-party payment services to process payments. The specific payment method(s) available for the respective goods will be shown to the customer in the respective offer of the seller or as part of the order processing. Further information on and the terms of use of Etsy Payments can be found here: etsy.com/de/legal/etsy-payments/?ref=list
4.5 If advance payment by bank transfer is agreed, payment is due immediately after conclusion of the contract, unless the parties have agreed on a later due date.
4.6 If the payment method "PayPal" is selected, payment processing is carried out via the payment service provider PayPal (Europe) S.à r.l. et Cie, S.C.A., 22-24 Boulevard Royal, L-2449 Luxembourg under the PayPal terms of use, which can be viewed at paypal.com/de/webapps/mpp/ua/useragreement-full. This requires, among other things, that the customer opens a PayPal account or already has such an account.
5) Delivery and shipping conditions
5.1 Goods are delivered by shipping to the delivery address provided by the customer, unless otherwise agreed. When processing the transaction, the delivery address specified in the order processing on Etsy is decisive. In contrast to this, if the PayPal payment method is selected, the delivery address provided by the customer to PayPal at the time of payment is decisive.
5.2 If the delivery of the goods fails for reasons for which the customer is responsible, the customer shall bear the reasonable costs incurred by the seller as a result. This does not apply to the costs of delivery if the customer effectively exercises his right of withdrawal. If the customer effectively exercises his right of withdrawal, the provisions in the seller's cancellation policy apply to the return costs.
5.3 The seller reserves the right to withdraw from the contract in the event of incorrect or improper self-delivery. This only applies if the seller is not responsible for the non-delivery and has concluded a specific hedging transaction with the supplier with due care. The seller will make all reasonable efforts to procure the goods. In the event of unavailability or only partial availability of the goods, the customer will be informed immediately and the consideration will be refunded immediately.
5.4 Digital content is provided to the customer as follows:
- by download
5.5 Vouchers are provided to the customer as follows:
- by email
6) Granting of rights of use for digital content
6.1 Unless the seller's description of the content on Etsy states otherwise, the seller grants the customer the non-exclusive, geographically and temporally unlimited right to use the content provided exclusively for private purposes.
6.2 Passing on the content to third parties or making copies for third parties outside the scope of these terms and conditions is not permitted unless the seller has agreed to transfer the license to the third party.
6.3 If the contract relates to the one-time provision of digital content, the granting of rights only takes effect when the customer has paid the remuneration owed in full. The seller can also provisionally permit the use of the content provided before this point in time. A transfer of rights does not take place through such provisional permission.
7) Retention of title
7.1 The seller reserves title to the goods delivered to consumers until the purchase price owed has been paid in full.
7.2 The seller reserves title to the goods delivered to entrepreneurs until all claims from an ongoing business relationship have been settled in full.
8) Liability for defects
8.1 Unless otherwise stated in the following provisions, the provisions of statutory liability for defects apply. The following applies to contracts for the delivery of goods:
8.2 If the customer is an entrepreneur,
- the seller has the choice of the type of subsequent performance;
- for new goods, the limitation period for defects is one year from delivery of the goods;
- for used goods, rights and claims due to defects are excluded;
- the limitation period does not begin again if a replacement delivery is made within the scope of liability for defects. 8.3 The liability limitations and deadline reductions regulated above do not apply
- to the customer's claims for damages and reimbursement of expenses,
- in the event that the seller has fraudulently concealed the defect,
- to goods that have been used for a building in accordance with their usual use and have caused its defectiveness,
- to any existing obligation of the seller to provide updates for digital products in the case of contracts for the delivery of goods with digital elements.
8.4 In addition, for entrepreneurs, the statutory limitation periods for any existing statutory recourse claim remain unaffected.
8.5 If the customer acts as a merchant within the meaning of Section 1 of the German Commercial Code (HGB), he is subject to the commercial obligation to inspect and give notice of defects in accordance with Section 377 of the German Commercial Code (HGB). If the customer fails to comply with the notification obligations regulated there, the goods are deemed to have been approved.
8.6 If the customer is acting as a consumer, he is requested to complain to the deliverer about goods that have obvious transport damage and to inform the seller of this. If the customer does not do this, this will have no effect on his legal or contractual claims for defects.
Send feedback
Side panels
History
Saved
9) Liability
The seller is liable to the customer for all contractual, quasi-contractual and legal, including tortious claims for damages and reimbursement of expenses as follows:
9.1 The seller is liable without limitation for any legal reason
- in the event of intent or gross negligence,
- in the event of intentional or negligent injury to life, body or health,
- due to a guarantee promise, unless otherwise regulated in this regard,
- due to mandatory liability such as under the Product Liability Act.
9.2 If the seller negligently breaches a material contractual obligation, liability is limited to the foreseeable damage typical of the contract, unless unlimited liability is assumed in accordance with the above paragraph. Material contractual obligations are obligations that the contract imposes on the seller according to its content in order to achieve the purpose of the contract, the fulfillment of which makes the proper execution of the contract possible in the first place and on whose compliance the customer can regularly rely.
9.3 Otherwise, the seller's liability is excluded. 9.4 The above liability regulations also apply with regard to the seller's liability for its vicarious agents and legal representatives.
10) Special conditions for the processing of goods according to specific customer specifications
10.1 If, according to the content of the contract, the seller is obliged to process the goods according to specific customer specifications in addition to delivering the goods, the customer must provide the operator with all content required for processing, such as texts, images or graphics, in the file formats, formatting, image and file sizes specified by the operator and grant the operator the necessary rights of use for this purpose. The customer is solely responsible for the procurement and acquisition of rights to this content. The customer declares and assumes responsibility for having the right to use the content provided to the seller. In particular, he ensures that no third-party rights are violated, in particular copyright, trademark and personal rights.
10.2 The customer indemnifies the seller against claims made by third parties in connection with a violation of their rights through the contractual use of the customer's content by the seller. The customer also assumes the reasonable costs of the necessary legal defense, including all court and attorney fees at the statutory rate. This does not apply if the customer is not responsible for the violation of law. In the event of a claim by third parties, the customer is obliged to provide the seller with all information that is necessary for examining the claims and for a defense, immediately, truthfully and completely.
10.3 The seller reserves the right to reject processing orders if the content provided by the customer violates legal or official prohibitions or violates common decency. This applies in particular to the provision of content that is unconstitutional, racist, xenophobic, discriminatory, offensive, harmful to young people and/or glorifies violence.
11) Applicable law
The law of the Federal Republic of Germany applies to all legal relationships between the parties, excluding the laws on the international sale of movable goods. For consumers, this choice of law only applies to the extent that the protection granted is not withdrawn by mandatory provisions of the law of the state in which the consumer has his habitual residence.
12) Alternative dispute resolution
12.1 The EU Commission provides a platform for online dispute resolution on the Internet at the following link: https://ec.europa.eu/consumers/odr
This platform serves as a contact point for the out-of-court settlement of disputes arising from online sales or service contracts in which a consumer is involved.
12.2 The seller is neither obliged nor willing to participate in a dispute resolution procedure before a consumer arbitration board.
––––––––––––––––––––––––––––––––––––
B. Information on data protection
–––––––––––––––––––––––––––––––––––––––
1) Information on the collection of personal data and contact details of the controller
1.1 We are pleased that you are visiting our Etsy site (hereinafter "website") and thank you for your interest. In the following we will inform you about how your personal data is handled when you use our website. Personal data is all data with which you can be personally identified.
1.2 The person responsible for data processing within the meaning of the General Data Protection Regulation (GDPR) is Maria Kuznetsova, Marachowska ART, Kopenhagener Str., 73, 10437 Berlin, Germany, Tel.: +4917664874208, E-Mail: marachowska@gmail.com. The person responsible for the processing of personal data is the natural or legal person who, alone or jointly with others, decides on the purposes and means of processing personal data.
2) Contact
When you contact us (e.g. via contact form or email), personal data is collected. You can see what this is from the contact form. This data is stored and used exclusively for the purpose of answering your request or for contacting you and the associated technical administration. The legal basis for processing the data is our legitimate interest in answering your request in accordance with Art. 6 Para. 1 lit. f GDPR. If your contact is aimed at concluding a contract, the additional legal basis for processing is Art. 6 Para. 1 lit. b GDPR. Your data will be deleted after your request has been finally processed; this is the case if it can be inferred from the circumstances that the matter in question has been conclusively clarified and provided that there are no statutory retention periods to the contrary.
3) Data processing for order processing
3.1 To the extent necessary for contract processing for delivery and payment purposes, the personal data we collect will be passed on to the commissioned transport company and the commissioned credit institution in accordance with Art. 6 (1)(b) GDPR.
If we owe you updates for goods with digital elements or for digital products on the basis of a corresponding contract, we will process the contact details you provided when ordering (name, address, email address) in order to inform you personally about upcoming updates within the legally stipulated period by suitable communication channels (e.g. by post or email) within the scope of our statutory information obligations in accordance with Art. 6 (1)(c) GDPR. Your contact details will be used strictly for the purpose of notifications about updates owed by us and will only be processed by us for this purpose to the extent necessary for the respective information.
To process your order, we also work with the following service provider(s), who support us in whole or in part in the implementation of concluded contracts. Certain personal data is transmitted to these service providers in accordance with the following information.
3.2 - posterXXL
Orders are processed via the service provider "posterXXL" of posterXXL GmbH, Infanteriestraße 11a, 80797 Munich. Name, address and any other personal data will be passed on to posterXXL exclusively for the purpose of processing the online order in accordance with Art. 6 Para. 1 lit. b GDPR. Your data will only be passed on if this is actually necessary for processing the order. Details on posterXXL's data protection and the privacy policy of posterXXL GmbH can be viewed at posterxxl.de/datenschutzerklaerung.
- Printful
Orders are processed via the service provider "Printful" of Printful, Inc. 11025 Westlake Drive,
Charlotte, NC28273, USA. Name, address and any other personal data will be passed on to Printful exclusively for the purpose of processing the online order in accordance with Art. 6 Para. 1 lit. b GDPR. Your data will only be passed on to the extent that this is actually necessary for processing the order. Details on Printful's data protection and the privacy policy of Printful, Inc. can be viewed at printful.com/policies/privacy.
3.3 We work with external shipping partners to fulfill our contractual obligations to our customers. We pass on your name and delivery address to a shipping partner selected by us exclusively for the purposes of delivering goods (Art. 6 Para. 1 lit. b GDPR).
3.4 When using the Etsy Payments payment method, payment processing is carried out via Etsy Ireland UC, 66/67 Great Strand Street, Dublin 1, Ireland (hereinafter: Etsy UC), unless payment is made in US dollars or Canadian dollars. In this case, payment processing is carried out by Etsy Inc., 117 Adams Street, Brooklyn, NY 11201, United States of America (hereinafter: Etsy Inc.). The data is passed on in accordance with Art. 6 Para. 1 lit. b GDPR and only to the extent that this is necessary for payment processing.
For further information on data protection, please refer to Etsy's privacy policy: etsy.com/de/legal/privacy/
3.5 When paying by credit card via PayPal or by direct debit via PayPal, we pass on your payment data to PayPal (Europe) S.a.r.l. as part of the payment processing. et Cie, S.C.A., 22-24 Boulevard Royal, L-2449 Luxembourg (hereinafter "PayPal"). The data is passed on in accordance with Art. 6 Paragraph 1 Letter b of GDPR and only to the extent that this is necessary for payment processing.
4) Web analysis services
Google (Universal) Analytics
Etsy uses Google (Universal) Analytics, a web analysis service provided by Google Ireland Limited, Gordon House, 4 Barrow St, Dublin, D04 E5W5, Ireland ("Google"). Google (Universal) Analytics uses so-called "cookies", which are text files saved on your device that enable an analysis of your use of this website. The information generated by the cookie about your use of this website (including the shortened IP address) is usually transferred to a Google server and saved there; this may also involve transmission to the servers of Google LLC in the USA.
Google (Universal) Analytics is used exclusively with the extension "_anonymizeIp()", which ensures that the IP address is anonymized by shortening it and excludes direct personal reference. This extension means that your IP address is shortened beforehand by Google within member states of the European Union or in other contracting states to the Agreement on the European Economic Area. Only in exceptional cases will the full IP address be transmitted to a Google LLC server in the USA and shortened there.
On our behalf, Google will use this information to evaluate your use of the website, to compile reports on website activity and to provide us with other services related to use. The IP address transmitted by your browser as part of Google (Universal) Analytics will not be merged with other Google data.
Google Analytics also uses a special function, the so-called "demographic characteristics", to create statistics with statements about the age, gender and interests of site visitors based on an evaluation of interest-based advertising and with the use of third-party information. This allows the definition and differentiation of user groups of the website for the purpose of targeting marketing measures that are optimized for the target group. However, data records collected using the "demographic characteristics" cannot be assigned to a specific person.
Details on the processing initiated by Google Analytics and how Google handles data from websites can be found here: https://policies.google.com/technologies/partner-sites
All processing described above, in particular the setting of Google Analytics cookies for reading information on the device used, will only be carried out if you have given us your express consent in accordance with Art. 6 Paragraph 1 Letter a of GDPR. Without this consent, Google Analytics will not be used during your visit to the website.
You can revoke your consent at any time with effect for the future. To exercise your revocation, please deactivate this service in the "Cookie Consent Tool" provided on the website. We have concluded a data processing agreement with Google for the use of Google Analytics, which obliges Google to protect the data of our website visitors and not to pass it on to third parties. For the transmission of data from the EU to the USA, Google relies on the so-called standard data protection clauses of the European Commission, which are intended to ensure compliance with the European data protection level in the USA.
You can find further information on Google (Universal) Analytics here: https://policies.google.com/privacy?hl=de&gl=de
In connection with this website, the "UserIDs" function is also used as an extension of Google Analytics. By assigning individual user IDs, we can have Google create cross-device reports (so-called "cross device tracking"). This means that if you give your consent to the use of Google Analytics in accordance with Art. 6 Para. 1 lit. a GDPR, your usage behavior can also be analyzed across devices if you have set up a personal account by registering on this website and are logged into your personal account on different devices with your relevant login data. The data collected in this way shows, among other things, on which device you first clicked on an ad and on which device the corresponding conversion took place.
5) Rights of the data subject
5.1 The applicable data protection law grants you comprehensive rights as a data subject (rights to information and intervention) vis-à-vis the controller with regard to the processing of your personal data, about which we will inform you below:
- Right to information in accordance with Art. 15 GDPR: In particular, you have a right to information about your personal data processed by us, the purposes of the processing, the categories of personal data processed, the recipients or categories of recipients to whom your data has been or will be disclosed, the planned storage period or the criteria for determining the storage period, the existence of a right to rectification, erasure, restriction of processing, objection to processing, complaint to a supervisory authority, the origin of your data if it was not collected from you by us, the existence of automated decision-making including profiling and, if applicable, meaningful information about the logic involved and the scope and intended effects of such processing concerning you, as well as your right to be informed of the guarantees in accordance with Art. 46 GDPR when your data is forwarded to third countries;
- Right to rectification in accordance with Art. 16 GDPR: You have the right to have incorrect data concerning you rectified immediately and/or to have incomplete data stored by us completed;
- Right to erasure in accordance with Art. 17 GDPR: You have the right to request the erasure of your personal data if the requirements of Art. 17 Para. 1 GDPR are met. However, this right does not apply in particular if the processing is necessary to exercise the right to freedom of expression and information, to fulfil a legal obligation, for reasons of public interest or to assert, exercise or defend legal claims;
- Right to restriction of processing in accordance with Art. 18 GDPR: You have the right to request restriction of processing of your personal data as long as the accuracy of your data, which you dispute, is being verified, if you refuse to delete your data due to inadmissible data processing and instead request restriction of processing of your data, if you need your data to assert, exercise or defend legal claims after we no longer need this data after the purpose has been achieved or if you have lodged an objection for reasons related to your particular situation, as long as it has not yet been determined whether our legitimate reasons prevail;
- Right to information in accordance with Art. 19 GDPR: If you have asserted the right to rectification, erasure or restriction of processing vis-à-vis the responsible party, this party is obliged to inform all recipients to whom the personal data concerning you was disclosed of said rectification or erasure of the data or restriction of processing, unless doing so should prove impossible or involve disproportionate expenditure. You have the right to be informed of these recipients.
- Right to data portability in accordance with Art. 20 GDPR: You have the right to receive your personal data that you have provided to us in a structured, common and machine-readable format or to request that it be transmitted to another responsible party, insofar as this is technically feasible;
- Right to revoke consent granted in accordance with Art. 7 Para. 3 GDPR: You have the right to revoke consent to the processing of data once given at any time with effect for the future. In the event of revocation, we will delete the data concerned immediately unless further processing can be based on a legal basis for processing without consent. The revocation of consent does not affect the legality of the processing carried out on the basis of the consent until the revocation;
- Right to lodge a complaint pursuant to Art. 77 GDPR: If you consider that the processing of personal data concerning you violates the GDPR, you have the right to lodge a complaint with a supervisory authority, in particular in the Member State of your residence, place of work or place of the alleged infringement, without prejudice to any other administrative or judicial remedy.
5.2 RIGHT TO OBJECT
IF WE PROCESS YOUR PERSONAL DATA BASED ON OUR OVERRIDING LEGITIMATE INTEREST AS PART OF A BALANCING OF INTERESTS, YOU HAVE THE RIGHT TO OBJECT TO THIS PROCESSING AT ANY TIME FOR REASONS ARISING FROM YOUR PARTICULAR SITUATION, WITH EFFECT FOR THE FUTURE.
IF YOU EXERCISE YOUR RIGHT TO OBJECT, WE WILL STOP PROCESSING THE DATA IN QUESTION. HOWEVER, WE RESERVE THE RIGHT TO FURTHER PROCESSING IF WE CAN PROVE COMPELLING LEGITIMATE GROUNDS FOR THE PROCESSING WHICH OVERRIDE YOUR INTERESTS, FUNDAMENTAL RIGHTS AND FREEDOMS, OR IF THE PROCESSING SERVES THE ASSERTION, EXERCISE OR DEFENSE OF LEGAL CLAIMS.
IF WE PROCESS YOUR PERSONAL DATA IN ORDER TO CARRY OUT DIRECT MARKETING, YOU HAVE THE RIGHT TO OBJECT AT ANY TIME TO THE PROCESSING OF PERSONAL DATA CONCERNING YOU FOR THE PURPOSE OF SUCH ADVERTISING. YOU CAN EXERCISE THE OBJECTION AS DESCRIBED ABOVE.
IF YOU EXERCISE YOUR RIGHT OF OBJECTION, WE WILL STOP PROCESSING THE DATA CONCERNED FOR DIRECT MARKETING PURPOSES.
6) Duration of storage of personal data
The duration of storage of personal data is determined by the respective legal basis, the purpose of processing and - if applicable - also by the respective statutory retention period (e.g. retention periods under commercial and tax law).
When personal data is processed on the basis of an express consent in accordance with Art. 6 Para. 1 lit. a GDPR, this data is stored until the person concerned revokes their consent.
If there are statutory retention periods for data that are processed as part of legal or quasi-legal obligations on the basis of Art. 6 (1) (b) GDPR, these data will be routinely deleted after the retention periods have expired, provided that they are no longer required to fulfill or initiate a contract and/or we have no legitimate interest in continuing to store them.
When processing personal data on the basis of Art. 6 (1) (f) GDPR, these data will be stored until the data subject exercises his or her right of objection in accordance with Art. 21 (1) GDPR, unless we can demonstrate compelling legitimate reasons for the processing that outweigh the interests, rights and freedoms of the data subject, or the processing serves to assert, exercise or defend legal claims.
When personal data is processed for the purpose of direct advertising on the basis of Art. 6 (1) (f) GDPR, this data will be stored until the data subject exercises his or her right of objection in accordance with Art. 21 (2) GDPR.
Unless the other information in this declaration on specific processing situations indicates otherwise, stored personal data will otherwise be deleted when it is no longer necessary for the purposes for which it was collected or otherwise processed.
7) Reference to the Etsy privacy policy
The Etsy platform is responsible for all other data processing that goes beyond the data processing described above. You can find more information about Etsy's data protection in Etsy's privacy policy: etsy.com/de/legal/privacy/?ref=ftr
––––––––––––––––––––––––
C. Cancellation policy
–––––––––––––––––––––––
Right of cancellation
You have the right to cancel this contract within fourteen days without giving any reason.
For contracts for the delivery of goods, the cancellation period is fourteen days from the day on which you or a third party named by you, who is not the carrier, took possession of the last goods.
For contracts for the delivery of data that is not stored on a physical data carrier and is produced and provided in digital form (digital content), the cancellation period is fourteen days from the day on which the contract is concluded.
To exercise your right of cancellation, you must inform us (Maria Kuznetsova, Marachowska ART, Kopenhagener Str., 73, 10437 Berlin, Germany, Tel.: +4917664874208, E-Mail: marachowska@gmail.com) of your decision to cancel this contract by means of a clear statement (e.g. a letter sent by post or e-mail). You can use the attached sample cancellation form for this purpose, but this is not mandatory.
To meet the cancellation deadline, it is sufficient that you send the notification of the exercise of the right of cancellation before the cancellation period has expired.
Consequences of cancellation
If you cancel this contract, we will refund all payments that we have received from you, including delivery costs (with the exception of additional costs resulting from your choosing a different type of delivery than the cheapest standard delivery offered by us), promptly and at the latest within fourteen days from the day on which we received notification of your cancellation of this contract. For this refund, we will use the same means of payment that you used for the original transaction, unless something else was expressly agreed with you; under no circumstances will you be charged any fees for this refund.
For contracts for the delivery of goods, we may refuse to refund until we have received the goods back or until you have provided evidence that you have returned the goods, whichever is earlier.
You must return or hand over the goods to us promptly and in any event no later than twenty-one days from the date on which you notify us of the cancellation of this contract. The deadline is met if you send the goods before the expiry of the twenty-one day period.
You bear the direct costs of returning the goods. The direct costs of returning goods are estimated at a maximum of around 100 euros for each such item for goods that cannot normally be returned to us by post due to their nature (freight goods).
You only have to pay for any loss of value of the goods if this loss of value is due to handling of the goods that is not necessary to check their quality, properties and functioning.
Exclusion or premature expiration of the right of withdrawal
The right of withdrawal does not apply to contracts for the delivery of goods that are not prefabricated and for whose production an individual selection or determination by the consumer is decisive or which are clearly tailored to the personal needs of the consumer.
The right of withdrawal expires prematurely for contracts for the delivery of sound or video recordings or computer software in a sealed package if the seal was removed after delivery.
The right of withdrawal expires prematurely for contracts for the provision of digital content if we have begun to fulfil the contract after you have expressly agreed that we may begin to fulfil the contract before the expiry of the withdrawal period, you have confirmed to us that you are aware that by giving your consent you will lose your right of withdrawal when the contract begins to be fulfilled, and we have provided you with a confirmation of the contract on a durable medium in which the content of the contract, including the aforementioned conditions for the premature expiry of the right of withdrawal, is reproduced.
–––––––––––––––––––––
D. Cancellation form
––––––––––––––––––––––
If you want to cancel the contract, please fill out this form and send it back. To
Maria Kuznetsova
Marachowska ART
Kopenhagener Str., 73
10437 Berlin
Germany
E-mail: marachowska@gmail.com
I/we (*) hereby revoke the contract concluded by me/us (*) for the purchase of the following goods (*)/the provision of the following service (*)
_______________________________________________________
_______________________________________________________
Ordered on (*) ____________ / received on (*) __________________
________________________________________________________
Name of the consumer(s)
________________________________________________________
Address of the consumer(s)
________________________________________________________
Signature of the consumer(s) (only if notification is made on paper)
_________________________
Date
(*) Delete as appropriate
Copyright notice: These terms and conditions were drawn up by the specialist lawyers of the IT law firm and are protected by copyright (https://www.it-recht-kanzlei.de)
Status: 03.12.2022, 23:51:56
Frequently Asked Questions
Care instructions
GLASS PAINTINGS:
- The glass painting can be unhesitatingly cleaned with water and a soft cloth.
- In order to add extra brilliance, it is possible to clean the glass painting with a mild, ethanol free glass cleaner and a soft cloth
SHIPPING:
- Safe and secure worldwide shipping, cardboard packaged and additionally protected in bubble wrap
- with tracking number (International + EU)
USE:
- Window decoration (appropriate, residue-free removable mounting aids are included in the delivery)
- Table and windowsill decoration (transparent stand included)
- Optional framing for wall decoration
OFFER: 25% off when you buy 3 items